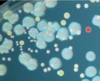

what shape is bacillus
rod
what shape is coccus
spheres/ round
what shape is spirochete
flexible, thin, spiral-shaped rod
what shape is spirillum
rigid, spiral-shaped rod
what are pleomorphic bacteria
no defined shape, variety of shapes in one species
what is diplo
pair
what is strepto
chain
what is staphylo
grape-like cluster
what is tetrads
packets of 4 cells
what is sarcina
packet of 8 cells
what are the three main types of cell walls that bacteria have
gram-negative
gram positive
acid-fast
what are the main components common to all three cell wall types of bacteria
peptidoglycan
lipoprotein
(provide structure support)
what is the peptidoglycan layer made up of?
backbone
tetra peptide side chains
peptide cross-bridge
what are the antimicrobial enzymes found in secretions and granules of peripheral mononuclear cells? and what is their function?
lysozymes
-weakens the cell integrity
do gram positive bacteria have a thick or thin peptidoglycan layer
thick
do gram negative bacteria have a thick or thin peptidoglycan layer?
thin
what is the primary stain
crystal violet
what is the counterstain
safranin
what color are gram negative cells
they retain the counter stain so they are red
what color are the gram positive cells
they retain the primary stain and stain purple
what is the periplasmic space
space between the inner and outer membrane
what is a distinct component of the outer layer of gram negative cells
lipopolysaccharides (LPS)
LPS is also known as
endotoxin
what structures is the LPS composed of
O antigen
core polysaccharide
lipid A